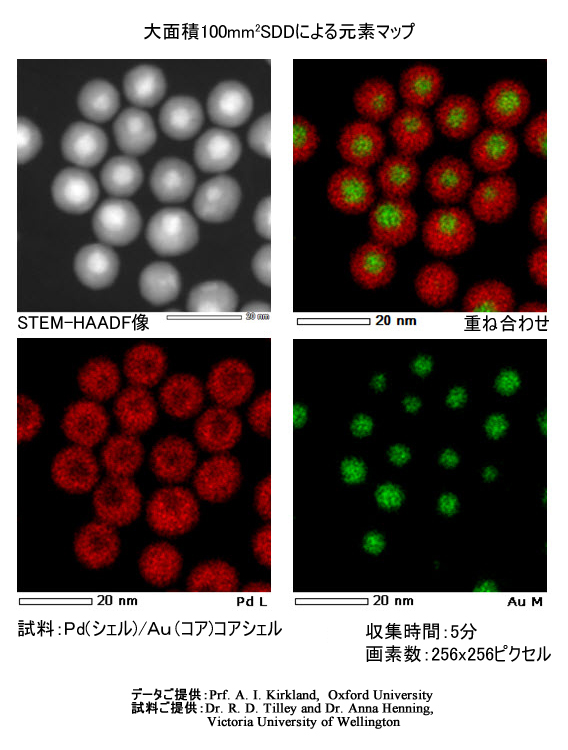

JEM-2800具有出色的可用性,并且集高分辨率观察和高速分析于一体的 TEM/STEM 设备。
功能
实现包括SEM在内的多种适合样品的观察模式
新设计的光学系统可实现高分辨率观察和高通量分析。 JEM-2800可以在透射图像(TEM)、扫描透射图像(STEM)、二次天游web原生态手机端图像和天游web原生态手机端衍射观察模式之间即时切换,使得在明亮的房间中观察图像成为可能。此外,在扫描图像模式下,可以同时观察STEM-BF图像、STEM-DF图像和二次天游web原生态手机端图像。这些功能使操作员能够根据目标以所需的观察模式轻松获取从各种样品结构到亚纳米晶格图像的所有图像。
自动功能和用户导航的高效操作环境
我们积极采用天游web原生态手机端显微镜观察所需的自动功能(对比度和亮度、样品高度(Z)调整、晶体取向对准、聚焦和像散校正)。这些功能使得获得可重复的结果成为可能,而与操作员的熟练程度无关。
此外,涡轮分子泵的标准设备减少了样品交换时间,插入样品架后约 30 秒即可开始观察。
此外,它还标配了操作员辅助系统JEM-Navi™,其中包括数据采集所需的操作指南和视频,因此即使是初学者也可以安全可靠地操作。
使用大面积 100mm² SDD 进行高速分析(兼容双 SDD)
不仅可以进行高通量观察,还可以进行高通量元素分析。 JEOL 的大面积 100mm² 硅漂移探测器 (SDD)※1,可以在不影响天游web原生态手机端显微镜性能的情况下获得大立体角,从而可以比传统方法更快地进行高效X射线分析。此外,JEM-2800允许您根据样品和分析方法选择最佳的天游web原生态手机端探针直径,以便在短时间内获得可靠的分析结果。
※1个选项
集成数据管理和报告创建支持
为了满足众多用户的需求,我们准备了一套全面的数据管理系统,可以快速报告分析结果。使用 JEM-2800 获取的图像和分析数据通过 LAN 传输到数据集成管理软件(图像中心※2) 将自动发送。此外,您可以从客户端 PC 访问它来测量长度 (Image Excite)。※2)和粒子分析(区域测量中心※2)可以高效执行数据组织软件(Image Import※2) 允许您轻松创建报告。
※2 System Infrontia Co, Ltd 制造
规格/选项
| 分辨率 | |
|---|---|
| 二次天游web原生态手机端图像(边到边) | ≤05nm(加速电压200kV) |
| 扫描传输图像 | 016nm(加速电压200kV) |
| 透射图像(点阵图像) | 01nm(加速电压200kV) |
| 放大倍数(在 24 英寸宽屏 LCD 上) | |
| 二次天游web原生态手机端图像 | X100~X150,000,000 |
| 扫描传输图像 | X100~X150,000,000 |
| 透明图像 | X500~X20,000,000 |
| 天游web原生态手机端枪 | |
| 天游web原生态手机端枪 | 肖特基场发射天游web原生态手机端枪 |
| 加速电压 | 200kV、100kV |
| 示例系统 | |
| 舞台 | Eucentric 侧入测角仪平台 |
| 样本大小 | 3mmΦ |
| 最大倾斜角度 | X轴:±20° Y轴:±25°(使用2轴倾斜支架时) |
| 移动范围 | X,Y: ±1mm Z: ±02mm (电机驱动)*兼容压电驱动器(X、Y) |
| 选项 | |
| 主要可安装选项 | 能量色散X射线光谱仪(EDS)天游web原生态手机端能量损失谱仪 (EELS)数字CCD摄像系统TEM/STEM 断层扫描系统 |
申请
与 JEM-2800 相关的应用
威尔逊病动物模型 LEC 大鼠肝脏的天游web原生态手机端显微镜研究和 X 射线探针微量分析
图库